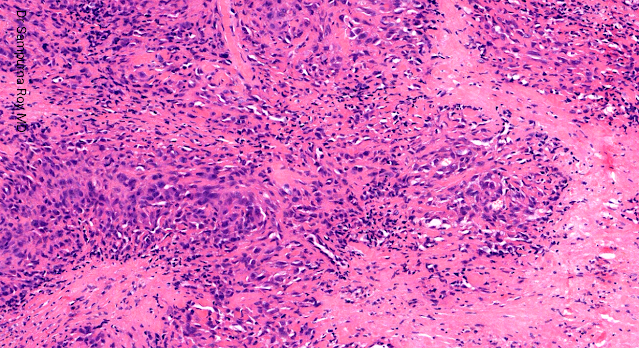

Dermatopathology Case 190
A 27-year-old man was referred to the dermatology department with a
3-month history of a rapidly growing painful mass on his right forearm
which subsequently ulcerated.
Immunohistochemical staining shows that the cells are positive for both mesenchymal markers smooth muscle actin and CD34 and epithelial markers cytokeratin and epithelial membrane antigen.

Comments
Post a Comment